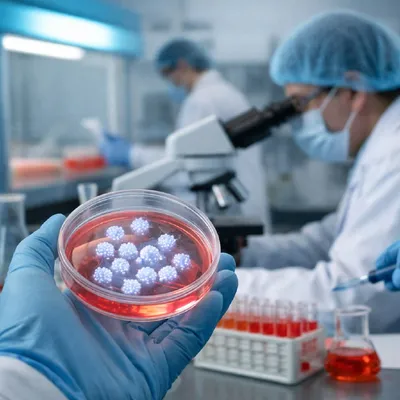

CLAMO.uz | Официалный канал
МедицинаОфициальный Telegram-канал на русском языке Центра лицензирования и аккредитации медицинских организаций – @CLAMOru 🌐 Официальный сайт: clamo.uz 📷 Instagram: instagram.com/clamo.uz 📘 Facebook: facebook.com/CLAMORasmiy 📍 г. Ташкент, ул. Паркент, дом 5
Мониторьте этот канал — посты, тренды, конкуренты
Обзор канала
- Платформа Telegram
- Категория Медицина
- Подписчики 5 220
- Температура Тёплый
- Постов/день 0.3
- Тип Публичный
Динамика подписчиков
Это ваш канал?
Подключите TeleGraphyx Traffic и получайте целевых подписчиков от 15₽. Интеграция с Яндекс.Директ, готовые лендинги, ежедневные отчёты.
Анализ публикаций
30 днейТипы контента
Популярные посты
#почтение 😊 В Центре лицензирования и аккредитации медицинских организаций состоялось праздничное мероприятие, посвящённое 8 Марта – Международному женскому дню. 💐 В ходе мероприятия руководство и
#8марта Дорогие и милые женщины! Вы, словно лучи солнца, согреваете сердца и дарите надежду. Вы, словно цветок, распространяете нежность и красоту. Вы, словно море, обладаете глубиной и безграничн
#медицинская_деятельность #минимальные_требования 🧾 Минимальные требования к материально-технической базе, оборудованию и другим техническим средствам, необходимым для осуществления соответствующего

🌙 С праздником Рамазан хайит! От имени Центра лицензирования и аккредитации медицинских организаций поздравляем вас с этим светлым праздником. Пусть этот праздник принесёт мир, здоровье, благополуч
#встреча_с_молодежью #качество_в_медицине #награждение 🏛 Сегодня, 19 марта, в Central Asian University состоялась встреча со студентами, обучающимися по медицинскому направлению, с участием руководс
#в_регионах #семинар_тренинг 📍 В Джизаке состоялись открытый диалог и практический семинар для частных клиник 😊Руководство и специалисты Центра по лицензированию и аккредитации медицинских организ
#Новости_медицины #Диабет 🧬 Учёные нашли новый способ лечения диабета 1 типа Американские учёные объявили о новом научном исследовании, направленном на лечение диабета 1 типа. Исследователи из Univ
#эксперт_отвечает ❓ЕСЛИ В КЛИНИКЕ ДОБАВЛЯЕТСЯ НОВАЯ СПЕЦИАЛИЗАЦИЯ, НУЖНО ЛИ ПОЛУЧАТЬ НОВУЮ ЛИЦЕНЗИЮ? – Получение новой лицензии не требуется. В данном случае применяется порядок внесения изменений в
#качество_медицинских_услуг 😊 Руководство и ответственные сотрудники Центра лицензирования и аккредитации медицинских организаций приняли участие в заседании депутатской группы УзЛиДеП в Ташкентском
#эксперт_отвечает ❓ ЧТО ОТНОСИТСЯ К МИНИМАЛЬНЫМ ТРЕБОВАНИЯМ ДЛЯ ОСУЩЕСТВЛЕНИЯ МЕДИЦИНСКОЙ ДЕЯТЕЛЬНОСТИ? – В соответствии с установленным порядком в сфере здравоохранения, для осуществления медицинск
Похожие каналы
Подобраны AI по тематике и контенту
Обзор канала
- Платформа Telegram
- Категория Медицина
- Подписчики 5 220
- Температура Тёплый
- Постов/день 0.3
- Тип Публичный
Хотите контент как у лучших? AI сделает
AI изучит стиль топовых каналов в нише и создаст уникальные посты, обложки и стратегию для вашего канала. Полный автопилот — от идеи до публикации.
Подписывайтесь на наши каналы
Кейсы, лайфхаки и новости о продвижении в мессенджерах

